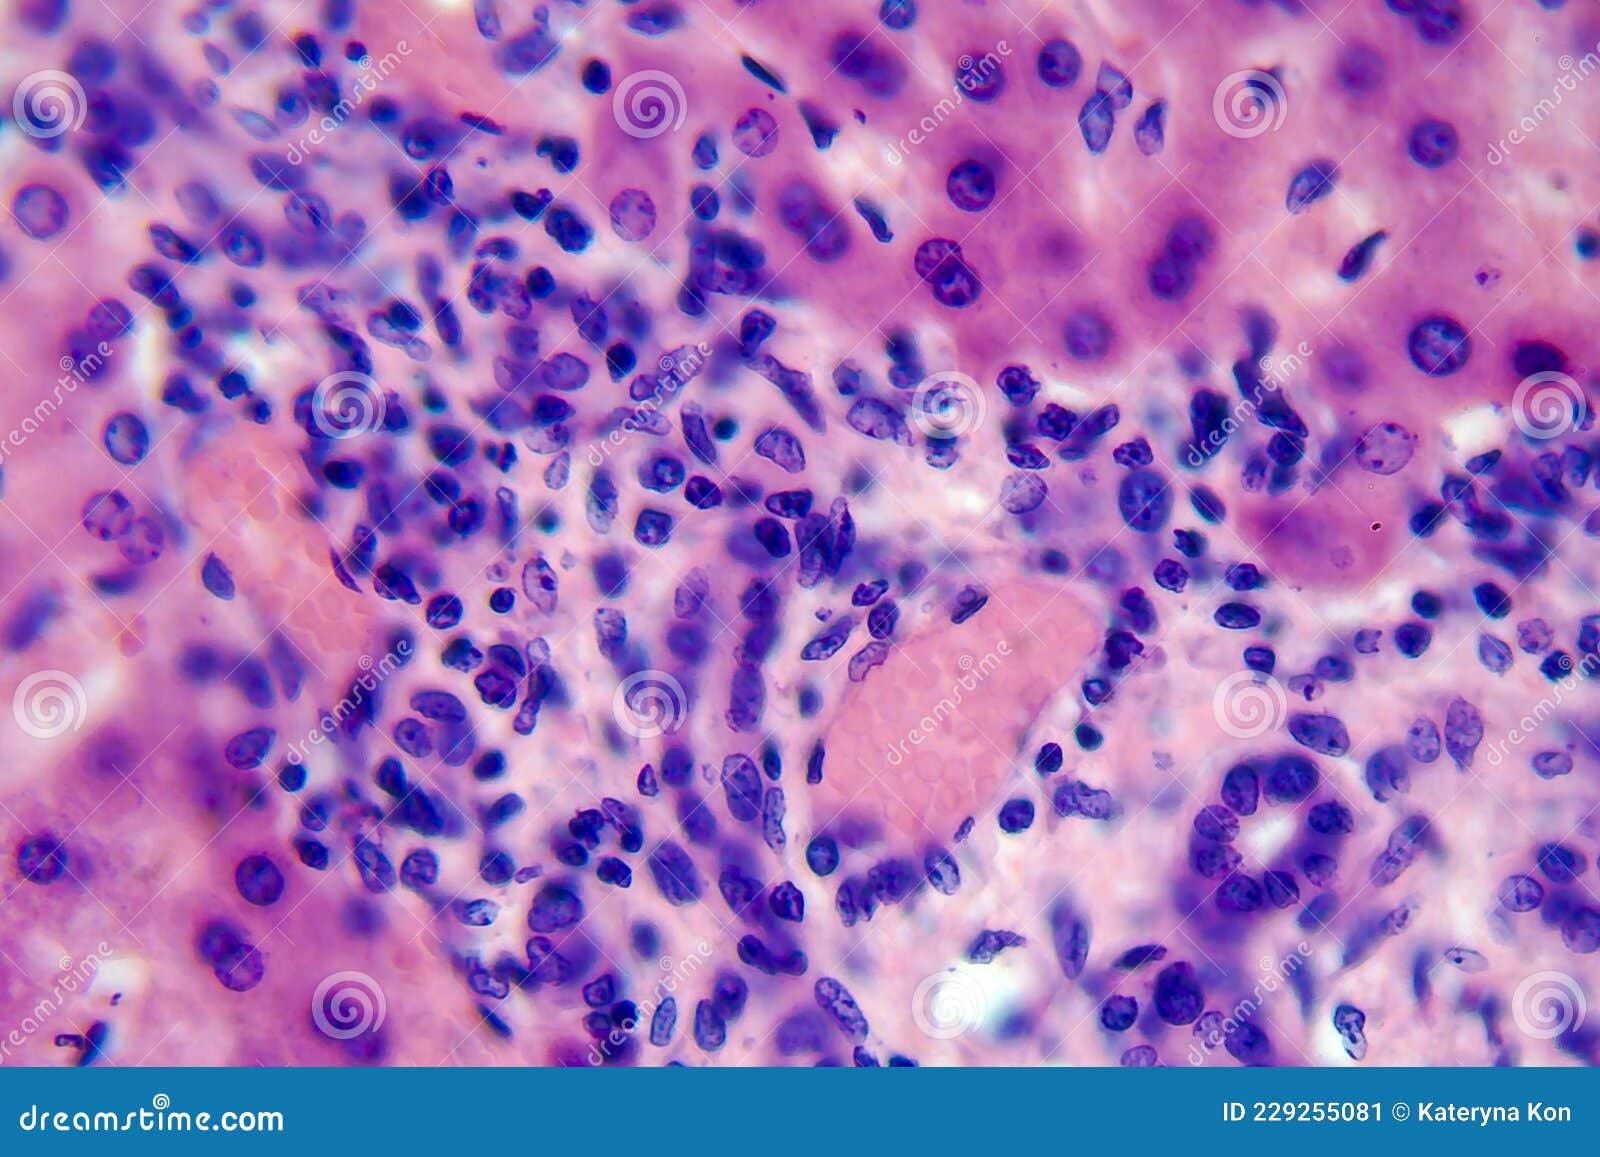

Кокцидиоз Печень Фото
Отель Босфорус Турция Фото
Комнатный Цветок Вампир Фото
Вирусная Пневмония Фото Легких
Петра Алексеева 19 Смоленск Фото
Гайморит Симптомы Фото
Участок Частного Дома Фото
Машина На Аккумуляторе Для Ребенка Фото
Осень Фото Красивые На Телефон Вертикальные
Ягоды Сахалина Фото
Дубаи Фото Голых Девушек
Чай Из Египта Фото И Название
Картошка Слоями В Духовке Фото
Фото Разметки В Магазинах От Коронавируса
Кокцидиоз Печень Фото 116 фото